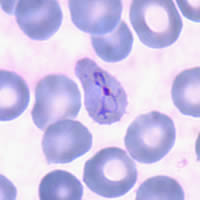
P. vivax ring - thin smear
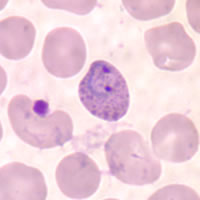
P. vivax ring - thin smear
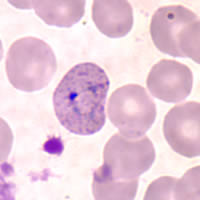
P. vivax ring - thin smear

|
|
[Last Modified: ] |
|
|
|
| [Plasmodium
falciparum] [Plasmodium malariae] [Plasmodium ovale] [Plasmodium vivax] |
Plasmodium vivax: Ring Stage Parasites
 |
Fig. 1: Normal
red cell; Figs. 2-6: Ring stage parasites (young trophozoites).
Illustrations from:
Coatney GR, Collins WE, Warren M, Contacos PG. The Primate Malarias. Bethesda: U.S.
Department of Health, Education and Welfare; 1971.
Smears from patients:
Plasmodium vivax rings have large chromatin dots and can show amoeboid cytoplasm as they develop. Red blood cells (RBCs) can be normal to enlarged up to 1 1/2× and may be distorted. Under optimal conditions, Schüffner's dots may be seen.
|
|
|
| A | B | C |
A, B, C: Rings in thin blood smears. A and C: Rings are amoeboid and the RBCs are enlarged and distorted. B: Ring with double chromatin dot. Schüffner's dots can be seen in B and C.
|
|||